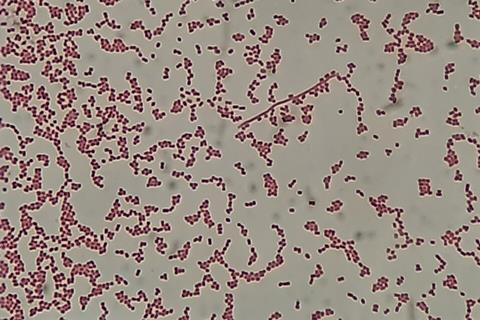
Gram_-negative_cocci_(GNC)_and_Gram_-negative_rod_(GNR)_of_Acinetobactet_baumannii_in_Gram_staining

Lethal lettuce in Missouri. Murderous onions in Colorado. To biochemists at the University of Oklahoma, these aren’t just headlines – they’re warnings of the risks posed by drug-resistant bacteria and the human cost of inaction.
“Treatment of chronic conditions and many surgeries requires antibiotics,” said Helen Zgurskaya, George Lynn Cross Research Professor in the OU Department of Chemistry and Biochemistry. “When bacteria become resistant to antibiotics and other drugs, many of our medical advances will also fail.”
READ MORE: Researchers discover method to overcome antimicrobial resistance
READ MORE: Studies probe how novel inhibitors can switch efflux pumps off in TB bacteria
Zgurskaya and Valentin Rybenkov, an OU professor of biochemistry, are leading a five-year, $5.3 million project funded by the National Institute of Allergy and Infectious Diseases to ensure that doesn’t happen. They aim to find new ways to deliver lifesaving drugs directly into resistant pathogens.
The work is essential. Without new medicines, experts predict that drug-resistant bacteria could kill as many as 2 million people annually by 2050.
When defenses fail
“We usually live together with bacteria; we depend on them for gut health and immunity,” Rybenkov said. “We also have ways to defend against harmful bacteria, if necessary. But occasionally our defenses fail. When this happens and they grow faster than they’re killed by our immune system, we need antibiotics.”
Unfortunately, bacterial resistance to the most common antibiotics is increasing rapidly worldwide. In October 2025, the World Health Organization reported that antibiotic resistance has been growing by as much as 15% annually, and that as many as 1 in 6 bacterial infections are resistant. In Southeast Asia and the eastern Mediterranean, it’s closer to 1 in 3.
In the search for remedies, Zgurskaya and Rybenkov have zeroed in on a class of pathogenic germs called gram-negative bacteria (GNB), which have evolved elaborate methods to protect their cell interiors from intruders, including antibiotics.
Two membranes - and a better efflux mechanism
Unlike gram-positive bacteria, which possess one cell membrane, GNB have two membranes, including a robust outer wall. Resistant bacteria also possess a stronger “efflux” mechanism – protein pumps designed to purge toxic substances from the cell’s interior. These defenses make it difficult for current classes of drugs to do their work.
To find holes in GNB defenses, Zgurskaya and Rybenkov are testing the permeation properties of about 2,000 chemicals and compounds against hundreds of efflux pump variants to identify candidates that could slip through the membranes of drug-resistant pathogens, including P. aeruginosa, E. coli, K. pneumoniae and A. baumannii. Once an initial atlas of viable compounds is created, the researchers plan to expand their work to study even more chemicals.
Protein pumps
They’re also studying how protein pumps work at the molecular level in a bid to identify new avoidance strategies.
“Think of a boat with a tiny hole,” Zgurskaya said. “Without intervention it will sink, slowly but surely. But if the boat has a water pump, it removes whatever accumulates. It’s a similar mechanism in gram-negative bacteria. Our job, as researchers, is to find a way to create a hole and turn off the pump.”
With the help of machine learning, laboratory results will be tested against an even bigger library of chemicals – “hundreds of thousands,” Zgurskaya said – to look for patterns and relationships that might point to new, more effective therapeutics.
“There is no easy way to predict what kind of molecule can get through a cell membrane,” Rybenkov said. “Artificial intelligence helps us navigate the data.”
Overuse of antibiotics
Overuse of antibiotics is often cited as the leading cause of bacterial resistance, but that’s only part of the story, Rybenkov said. “Bacteria want to spread; it’s a natural process,” he said. “We depend on bacteria for our way of life, but some bacteria don’t like us. To them, we’re just food.”
The OU researchers are collaborating on the project with Paolo Ruggerone, a professor in the Department of Physics at the University of Cagliari, Italy; John Walker, an associate professor of pharmacology and physiology at Saint Louis University; and ArrePath, a drug-discovery firm based in Princeton, New Jersey.
Topics
- Antimicrobial Resistance
- ArrePath
- Artificial Intelligence & Machine Learning
- Bacteria
- efflux pumps
- Gram-negative bacteria
- Helen Zgurskaya
- Infection Prevention & Control
- Infectious Disease
- John Walker
- One Health
- Paolo Ruggerone
- People News
- Pharmaceutical Microbiology
- Saint Louis University
- University of Cagliari
- University of Oklahoma
- USA & Canada
- Valentin Rybenkov
No comments yet